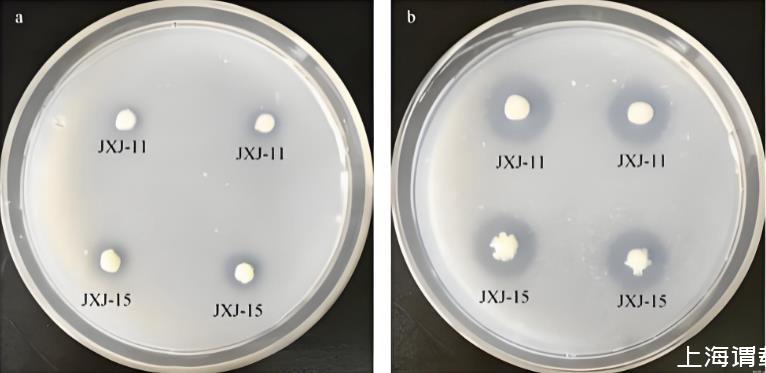

從技術機理到應用實踐,農業常用微生物有哪些功能作用?
當我們談論農業科技,腦海中往往浮現出大型智能農機、無人機遙感或基因編輯作物。然而,真正基礎性、顛覆性的變革,正發生在微觀尺度。這些微生物菌體并非現代科技的發明,而是我們終于學會了傾聽和利用這片古老而智慧的生命網絡。本文將深入挖掘農業中應用的各類微生物菌體,從技術機理到應用實踐,剖析這場靜默的農業革命。
農業常用微生物有哪些功能
1.酵母菌
功能:疏松土壤,增加土壤保水性,擴大根系面積。
作用:增強光合作用,減少肥料使用量,提高產量,改善品質。
2.乳酸菌
功能:分泌乳酸,具有較強的殺菌能力。
作用:
抑制有害微生物活動和有機物的急劇腐敗分解。
分解常態下不易分解的木質素和纖維素,促進有機物發酵分解。
抑制連作障礙導致的致病菌增殖,間接減少有害線蟲,改善植物生長狀態。
3.枯草芽孢桿菌
功能:增強作物抗逆性,具有固氮作用。
作用:
產生枯草菌素、多粘菌素等活性物質,抑制土壤致病菌。
通過溶菌作用抑制病原菌菌絲生長。
分泌類似植物激素的物質,促進植物生長并誘導抗性。
降解土壤中的菲與苯并芘等污染物,改善土壤呼吸強度和脲酶活性,助力鹽堿地改良。
4.光合菌
功能:在光照不足環境下增強作物光合作用。
作用:激活植物細胞活性,促進根系發育,提高光合效率和生殖生長能力。
5.涇陽鏈霉菌(5406)
特性:細黃鏈霉菌的乳糖變種。
作用:增強土壤肥力,刺激作物生長。對土壤病害效果顯著,72小時內對根結線蟲卵塊孵化抑制率達82.3%。
6.諾卡氏放線菌
作用:顯著防治土壤病害,對根結線蟲卵塊孵化抑制率達82.3%。
7.紅黃鏈霉菌
功能:多功能菌種。
作用:
加速有機物分解,釋放氮、磷、鉀等養分(轉化效率:氮5%~13%,磷7%~15%,鉀8%~16%)。
增強光合作用,誘導抗逆基因表達,提升作物對干旱、雨澇、低溫的抵抗能力。
分泌膠性物質改善土壤團粒結構,增強土壤透氣性、保水性和肥力。
8.巨大芽孢桿菌(磷細菌)
功能:解磷。
作用:高效降解土壤中的有機磷,釋放可利用的磷元素。
9.膠凍樣芽孢桿菌
功能:解鉀。
作用:釋放可溶性磷、鉀及鈣、硫、鎂、鐵、鋅等中微量元素。
10.解淀粉芽孢桿菌
作用:
分泌抗菌物質,抑制病原細菌、真菌、病毒和線蟲。
通過營養與空間競爭抑制病原物。
誘導植物產生抗性,分泌赤霉素等激素促進生長。
11.凝結芽孢桿菌
作用:降低環境中的氨氣、硫化氫等有害氣體,提高果實氨基酸含量。
12.側孢芽孢桿菌
作用:
促進根系生長,增強養分吸收,提高產量。
抑制病原菌繁殖,減輕病蟲害,降低農藥殘留。
改良土壤板結,活化土壤,提高肥料利用率。
增強光合作用,固化重金屬,降低植物體內重金屬含量。
13.地衣芽孢桿菌
作用:
抗病、殺滅有害菌,提升作物抗寒、抗旱能力。
增加土壤養分,改良結構,提高化肥利用率。
促進有機質分解成腐殖質,刺激作物生長,具有一定的固氮、解磷、解鉀作用。
14.菌根真菌
作用:擴大根系吸收面,增加對磷等元素的吸收能力。
15.米曲霉
作用:分解秸稈中的有機質,提升土壤有機質含量,改善土壤結構。
16.木霉菌
作用:
促進種子萌發和根系生長,增強植株活力。
分解纖維,用于病理防治,可添加至腐熟劑、有機肥中。
17.多粘類芽孢桿菌
作用:防治細菌和真菌性土傳病害,減少葉部病害,促進生長,增產。
18.多粘類芽孢桿菌(灌根)
作用:專用于灌根,防治土傳病害,減少葉部病害,促生長、增產。
19.凝結芽孢桿菌
作用:降低氨氣、硫化氫等有害氣體,提高果實氨基酸含量。
20.蠟質芽孢桿菌
作用:
防治土壤傳播的細菌性病害(如姜瘟病、青枯病)。
通過SOD酶提升作物抗逆性,加速生長,提高產量和品質。
21.蠟樣(狀)芽孢桿菌
作用:產生抗菌物質,抑制有害微生物,降解土壤養分,改善生態環境。
22.蘇云金芽孢桿菌
作用:殺蟲(包括根結線蟲),對鱗翅目等節肢動物有特異性毒殺活性。
23.淡紫擬青霉
作用:防治多種線蟲,是根結線蟲防治中最有前途的生防制劑。
24.白僵菌
作用:
專殺地下害蟲(如蠐螬、金針蟲、地老虎),可反復侵染,持效期長。
對松毛蟲、菜青蟲、玉米螟等害蟲防效顯著。
25.綠僵菌
作用:防治直翅目(蝗蟲)、鱗翅目(蛾類)等7目200多種昆蟲,對蠐螬、地老虎等地下害蟲效果理想。
26.哈茨木霉
作用:
在根圍形成“保護罩”,防止病原真菌侵染。
分泌酶和抗生素,分解病原真菌細胞壁,防治由腐霉菌、鐮刀菌等引起的病害。
27.日本金龜子芽孢桿菌
作用:金龜子專性寄生菌,感染蠐螬并引發A型乳化病。
28.球形芽孢桿菌
作用:
滅蚊病原微生物,對非靶生物無毒,不污染環境。
通過毒素蛋白毒殺蚊幼蟲,對蠐螬等害蟲有致病力。
29.湯普森多毛菌
作用:銹壁虱專一病原菌,有效防治柑橘等植物的銹壁虱。
30.厚孢輪枝菌
作用:兼性寄生菌,可腐生生活或寄生于根結線蟲、胞囊線蟲等,有效防治植物線蟲。
下面挑幾個進行詳細介紹:
一、固氮先鋒:大自然的“氮肥工廠”
在農業微生物的軍團中,固氮微生物無疑是最為耀眼的明星。它們的偉大之處在于,能夠將大氣中約占78%卻無法被植物直接利用的氮氣(N?),轉化為植物可吸收的氨(NH?)或銨鹽(NH??)。這一過程,相當于在植物根部建立了一座微型氮肥廠。
根瘤菌(Rhizobium)是其中最經典的例子。這類細菌與豆科植物(如大豆、花生、苜蓿)形成了精妙的共生關系。其技術核心在于一種復雜的分子對話:植物根系分泌特定的類黃酮物質,吸引對應的根瘤菌;根瘤菌則分泌結瘤因子,誘導植物根部形成特殊的結構——根瘤。在這個“合作車間”內,根瘤菌攜帶的固氮酶(一種對氧氣極度敏感的金屬酶復合體,堪稱生物界的精密儀器)在植物提供的低氧環境下,消耗大量能量,將N?的叁鍵斷裂,完成氮的固定。
技術深挖與亮點:根瘤菌-豆科植物的共生具有高度的專一性,這既是其高效性的保證,也是應用中的難點。現代生物技術正致力于拓寬這種共生關系的宿主范圍,例如嘗試讓根瘤菌與非豆科作物(如谷物)建立聯系,這將是農業史上的一個里程碑。此外,自生固氮菌(如圓褐固氮菌)和聯合固氮菌(如生活在禾本科植物根際的固氮螺菌)雖不形成根瘤,但也能在根際微域中貢獻可觀的氮素,其應用更方便,不受作物種類限制。
儀器視角:研究這些過程離不開高級工具。例如,利用穩定同位素1?N標記法,可以精準量化微生物的實際固氮效率;通過熒光原位雜交技術,可以直觀觀察到微生物在根際的定殖情況;而原子力顯微鏡等則能幫助我們窺探微生物-植物界面相互作用的物理細節。
二、養分解放者:磷、鉀的“鑰匙保管員”
除了氮,磷和鉀是植物生長的另外兩大關鍵元素。然而,土壤中95%以上的磷和鉀以難溶性礦物或有機態存在,植物只能“望洋興嘆”。此時,解磷微生物和解鉀微生物便扮演了“鑰匙保管員”的角色。
解磷微生物主要通過兩種機制工作:一是分泌有機酸(如檸檬酸、草酸),通過酸溶作用溶解磷礦;二是分泌磷酸酶(一種高效的生物催化劑),將有機磷礦化為可吸收的無機磷。杰出的代表有巨大芽孢桿菌和黑曲霉等。特別是真菌,其菌絲網絡能極大地擴展吸收范圍,像一張巨大的互聯網,將遠端的磷元素“輸送”給植物。
解鉀微生物,如膠質芽孢桿菌,則能分泌酸性物質和胞外多糖,破壞鉀長石、云母等礦物的晶體結構,釋放出鉀離子。
觀點與剖析:這類微生物的應用,極大地提高了肥料利用率,減少了因過量施用磷鉀肥造成的環境污染和水體富營養化。其技術亮點在于“精準釋放”:微生物的活動往往與植物的生長需求同步,在植物需要養分的時期最為活躍,這是一種智能的、按需供應的養分管理模式。
三、植物健康守護神:生物防治的“微型戰士”
化學農藥的濫用帶來了殘留、抗藥性和生態破壞等一系列問題。而生防微生物則提供了一條綠色、可持續的替代路徑。它們通過多種策略保護植物健康:
1.競爭作用:迅速占領植物的根際、葉際等生態位,搶奪空間和營養,讓病原菌“無立足之地”。例如,許多根際促生細菌都具備此能力。
2.拮抗作用:分泌抗生素、細菌素或細胞壁降解酶(如幾丁質酶),直接抑制或殺死病原菌。熒光假單胞菌和枯草芽孢桿菌是這方面的“多面手”,其基因組中含有多個抗生素合成基因簇,堪稱天然的抗生素工廠。
3.寄生作用:如木霉,其菌絲能纏繞并穿透病原真菌的菌絲,直接吸取營養。
4.誘導系統抗性:微生物或其代謝產物作為激發子,激活植物自身的防御系統,使植物處于“預警狀態”,對后續的病原菌入侵做出更快、更強的反應。這類似于給植物“接種疫苗”。
深度分析:生物防治的成功,關鍵在于菌株的篩選、發酵工藝和制劑化技術。一株優秀的生防菌,不僅要有強大的拮抗能力,還要能在田間復雜環境中穩定定殖和繁殖。這就需要通過高密度發酵、微膠囊包埋、與有機載體復合等工藝,確保菌劑在儲存、運輸和施用后仍能保持高活性。這背后是微生物學、發酵工程和材料科學的交叉融合。
四、土壤修復師與生長調節師
微生物的作用遠不止于提供養分和防治病害。它們還是至關重要的環境工程師。
降解菌,如某些鞘氨醇單胞菌和蒼白桿菌,能夠將土壤中的農藥殘留、石油烴等有機污染物作為“食物”進行降解,修復被污染的農田。
叢枝菌根真菌則與絕大多數陸地植物形成共生體。其龐大的菌絲網絡不僅是植物養分的“超級高速公路”,還能改善土壤團粒結構,增強土壤的保水保肥能力,幫助植物抵抗干旱等逆境。
此外,許多微生物還能分泌植物激素類似物,如印度梨形孢菌能產生赤霉素和生長素,直接促進植物生長。
挑戰與展望:從“知道”到“用好”的漫漫長路
盡管農業微生物前景廣闊,但我們仍需清醒地認識到其面臨的挑戰:
穩定性問題:田間環境復雜多變,菌劑的效果容易受到溫度、濕度、土壤pH值、土著微生物群落的影響,效果不穩定是目前產業化的最大瓶頸。
認知深度不足:我們目前對土壤微生物組的理解仍處于“冰山一角”階段。微生物之間、微生物與植物、環境之間構成了一個極其復雜的網絡。單一菌株的引入,能否在生態網絡中穩定占據一席之地,是需要深入研究的科學問題。
個性化定制:未來的趨勢可能不是“萬能菌劑”,而是需要根據不同作物、不同土壤類型、甚至不同種植模式,定制專用的微生物菌劑組合,這需要更精準的診斷和更靈活的生產技術。
結語
當我們俯身捧起一把泥土,我們手中捧起的是一個充滿生機的宇宙。農業微生物的應用,標志著人類從試圖征服自然,轉向學習與自然合作的智慧。它不僅僅是一種技術替代,更是一種農業哲學的轉變:從化學依賴的單一高投入模式,轉向基于生態學的、強調系統健康和可持續性的綜合管理策略。
這些微觀的盟友,默默地維系著地表生命的繁榮。未來的農業,必將是一場“宏觀”與“微觀”緊密結合的協奏曲。作為科研人員,我們的使命不僅是繼續挖掘這座微生物“金礦”,更是要設計出巧妙的“樂譜”,讓這些沉默的盟友,能夠在農田這個廣闊的舞臺上,奏出更加和諧、高效的生命樂章,共同守護我們這顆星球的糧食安全與生態未來。
相關新聞推薦
1、轉錄水平解析昆蟲病原線蟲共生菌菌株新型殺菌蛋白PPIA-L20基因表達調控——摘要、引言
2、羊奶或山羊奶中的乳清之開菲爾谷物的化合物代謝活動與生長變化
